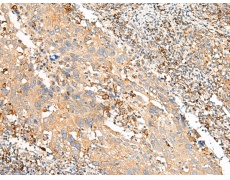
一抗

|
Background: |
This gene encodes a member of the G-protein-coupled receptor 1 family. G-protein coupled receptors are membrane proteins which activate signaling cascades as a response to extracellular stress. The encoded protein activates a Gq signal transduction pathway which mobilizes calcium. |
|
Applications: |
ELISA, IHC |
|
Name of antibody: |
GPR21 |
|
Immunogen: |
Synthetic peptide of human GPR21 |
|
Full name: |
G protein-coupled receptor 21 |
|
SwissProt: |
Q99679 |
|
ELISA Recommended dilution: |
5000-10000 |
|
IHC positive control: |
Human colorectal cancer and Human cervical cancer |
|
IHC Recommend dilution: |
30-150 |


 購(gòu)物車
購(gòu)物車 幫助
幫助
 021-54845833/15800441009
021-54845833/15800441009